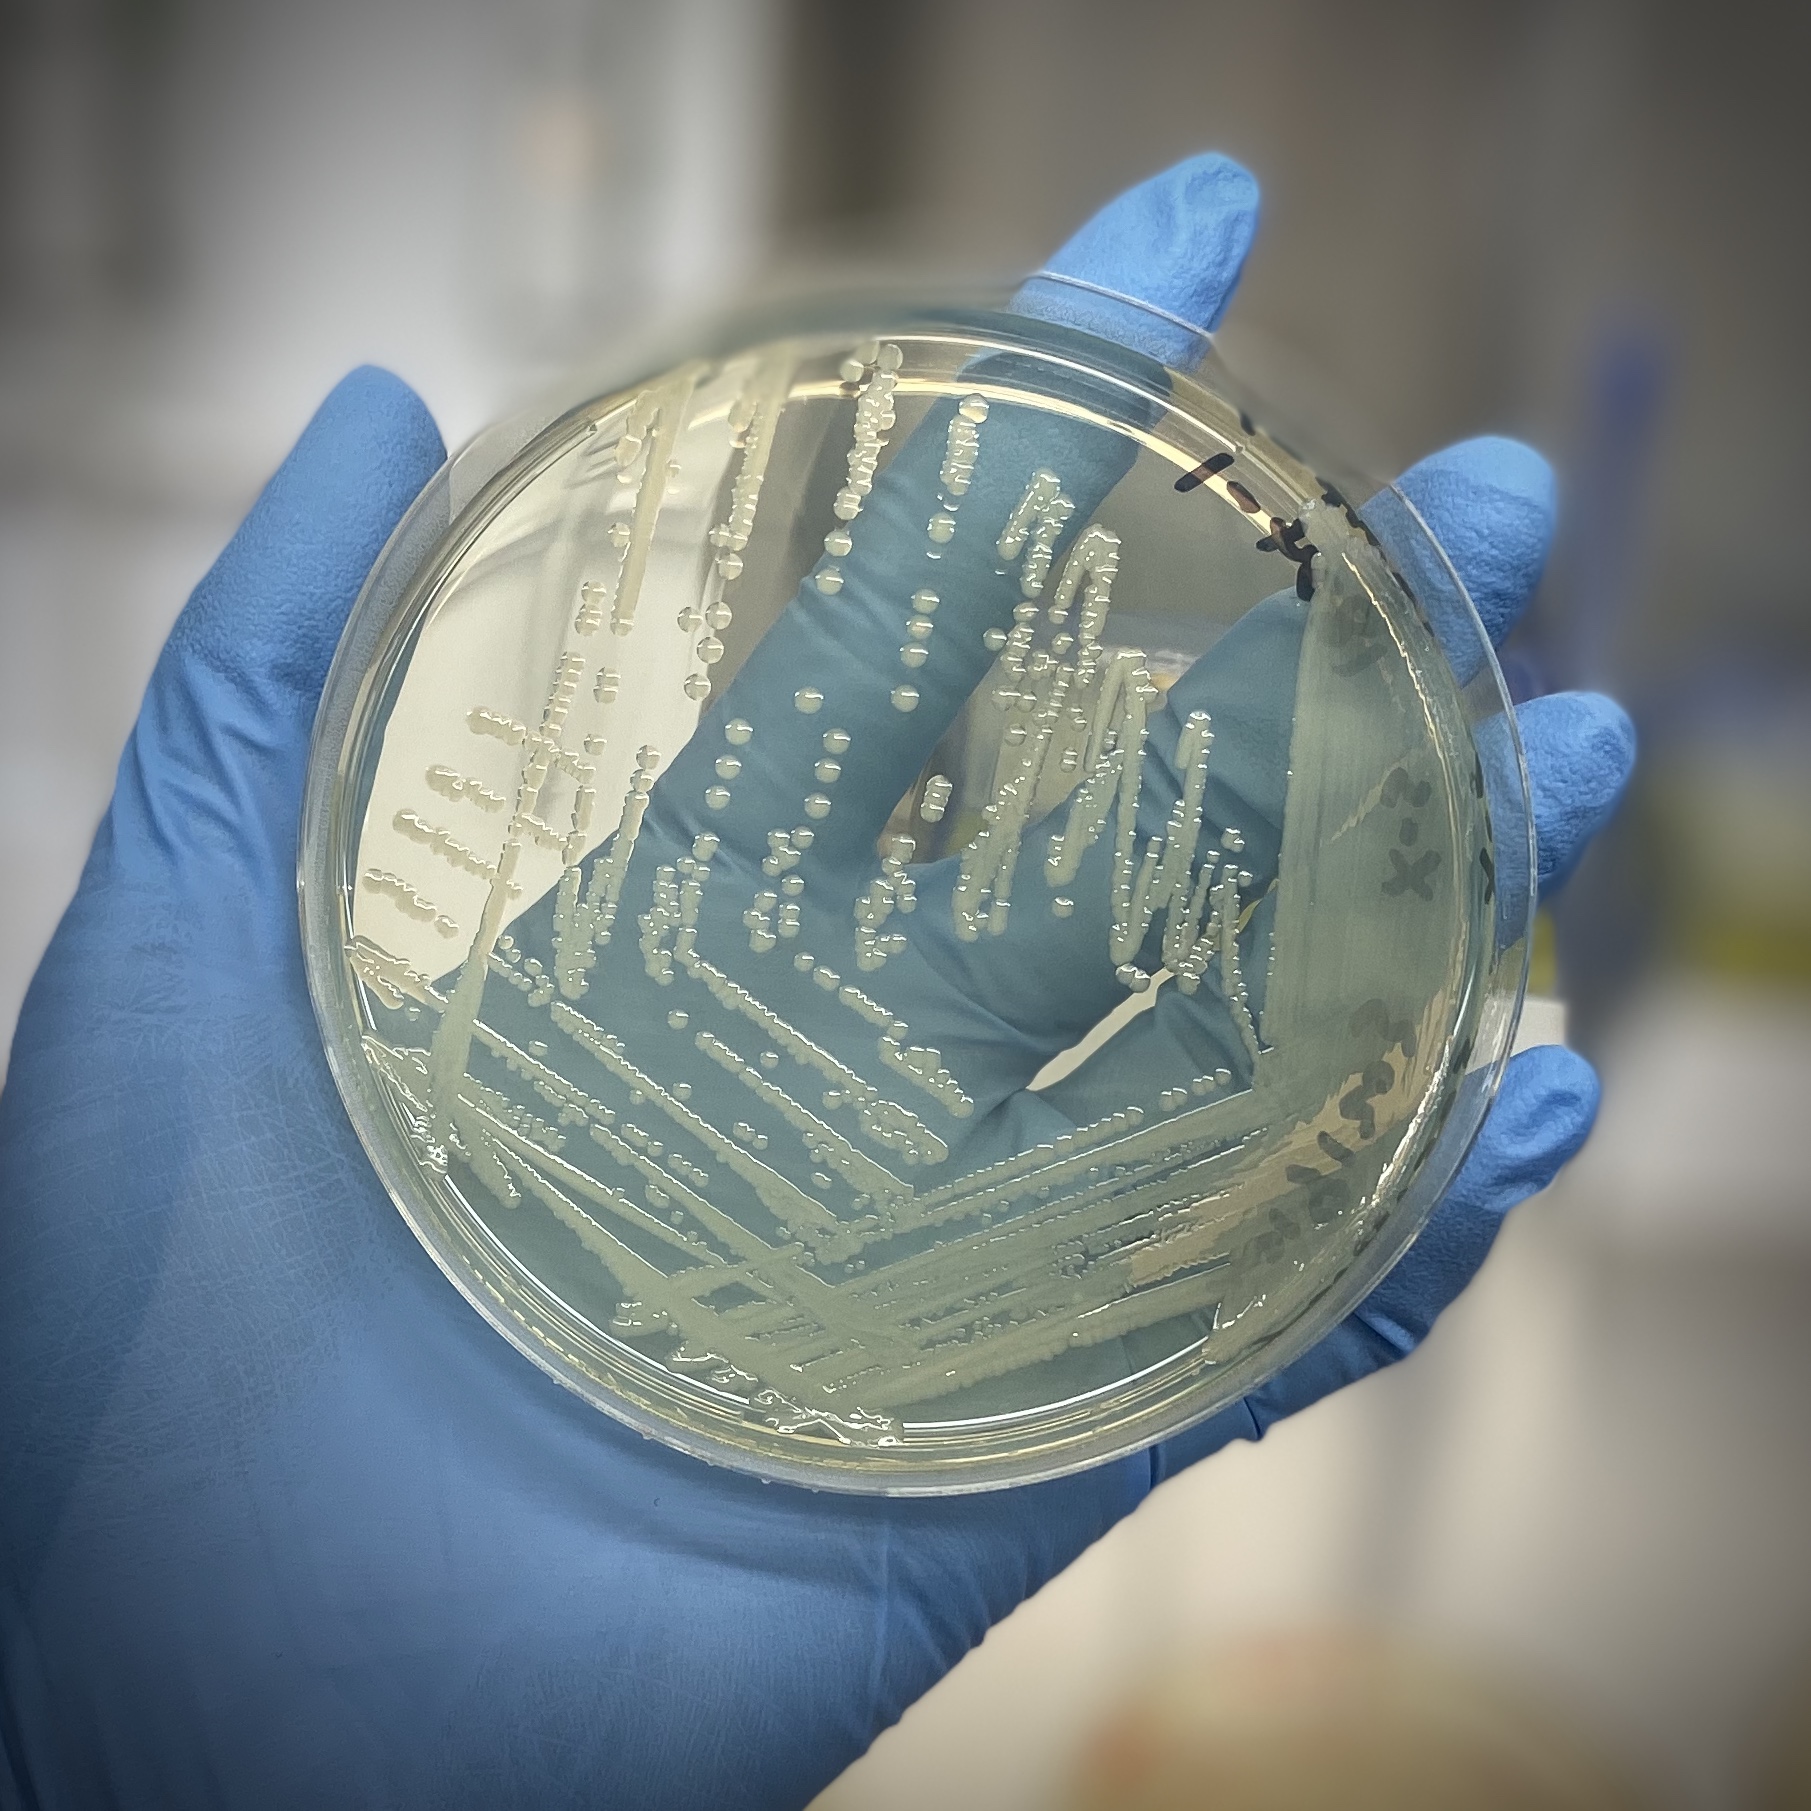
Micobial 9

玛氏食品安全中心最新活动: 国际食品矿物油分析研讨会
玛氏食品安全中心最新活动: 国际食品矿物油分析研讨会
2020年9月15 - 16日,玛氏全球食品安全中心将联合举办“食品矿物油分析”国际研讨会。
Contact Us2020年9月15 - 16日,玛氏全球食品安全中心将联合举办“食品矿物油分析”国际研讨会。
Contact Us今年8月,食安中心很荣幸参加了“保障未来粮食供给”减少收获后损失创新实验室(PHLIL)的线上年度会议。
7月22日,著名的2020年度美国微生物学会年度会议在线活动拉开帷幕,玛氏全球食品安全中心很荣幸在此平台展示电子学术海报。
玛氏公司食品安全科学与能力总监毕睿博(Robert C. Baker)近期在<New Food>杂志6月刊发表文章《保障每个人与宠物的食品安全——为什么合作至关重要》。
玛氏全球食品安全中心诚挚感谢在6月7日与我们携手庆祝第二届世界食品安全日的所有同事。
近日,玛氏全球食品安全中心受邀在由英国牛津纳米孔公司(Oxford Nanopore Technologies)主办的在线会议London Calling 2020上展示了关于微生物风险管理方面的前沿研究成果。
在食品安全方面,中国正通过人工智能(AI)、区块链和基因组学等新的颠覆性技术展望未来
作为中国美国商会科技创新项目(Technology and Innovation Initiative)的核心合作伙伴,玛氏中国一直致力于在美商会打造的技术创新企业社群中普及颠覆性技术对于食品行业的影响。
6月17日(星期三)上午,玛氏公司和中国美国商会将举办一场名为“从农场到餐桌: 科技助力食品安全”的网络研讨会。
Contact Us